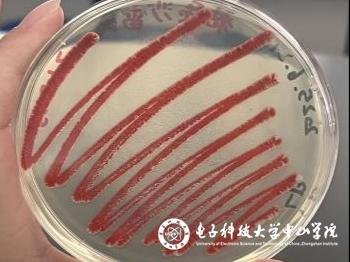
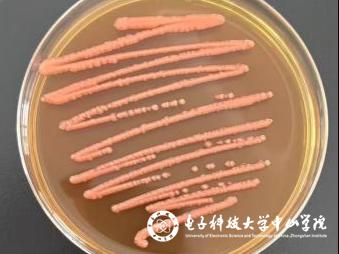

近日,一场融合了科学与艺术的创意盛宴——第三届生物发酵行业微生物培养皿艺术设计职业技能大赛,吸引了全国的目光。我校环境工程专业的同学们,以本次大赛为契机,带着他们的“细菌天团”登上这个面向全国的舞台,用实力和创意,向大家展示了环境工程专业有趣的一面!
此次竞赛由中国轻工业联合会、中国生物发酵产业协会等主办,紧扣生物发酵前沿,将微生物技术与艺术创作深度融合,吸引全国相关领域人才参与,充分挖掘创新潜力,推动学科跨界发展,是生物发酵行业极具影响力的年度赛事。



环工学子以实验室为画室,以接种环、灭菌毛笔等为画笔,培养基(肉汤培养基、LB培养基、麦芽汁培养基等)为画布,打开他们的专属“微生物颜料盘”,将课本上的知识,变成了一场奇妙的艺术实验。
“聚光灯”担当:发光明亮杆菌,这位“自带光环”的选手,能发出天然的蓝色荧光,为作品注入梦幻光影。

粘质沙雷氏菌,身披鲜明的“中国红”,是当之无愧的画面“C位”。
藤黄微球菌,拥有规整的菌落形态和鲜亮的黄色,是勾勒轮廓、构建纹理的“一把好手”。

深红酵母与黑酵母,则凭借独特的橙红与酷黑,以及与众不同的生长肌理,为画面增添了丰富的层次与质感。
“这次比赛彻底颠覆了我对专业的认知!”参赛团队的同学激动地分享道,“以前觉得微生物就是课本上那些枯燥的名字和图片,没想到通过亲手培养和设计,它们能‘活’起来,变成这么美丽的艺术品。这种把理论知识应用到创新实践中的感觉,真的太有成就感了!”
这份成就感,源于对专业知识的深刻理解,也源于无数次的尝试和团队协作。这,正是环境工程专业带给学生的独特成长体验。